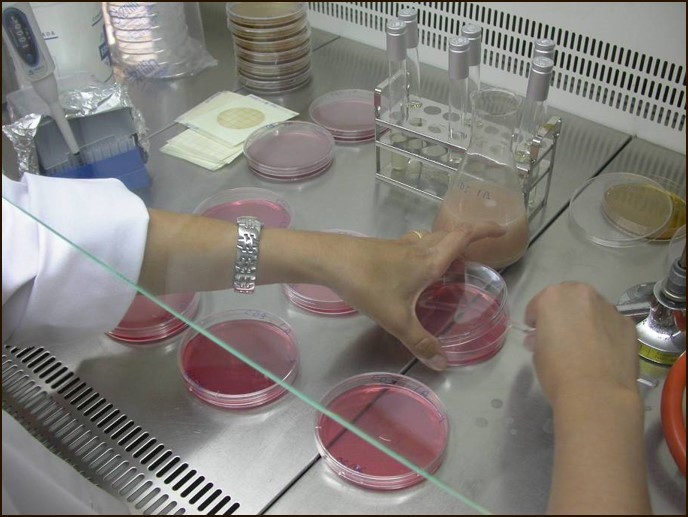

Iberic-Sensotracing es el innovador proyecto de investigación que tiene como objetivo mejorar la seguridad alimentaria en la producción de derivados cárnicos mediante la implantación de sensores. Estos dispositivos permitirán la monitorización en tiempo real de las diferentes fases del proceso productivo, ofreciendo un control más preciso y efectivo sobre la presencia de patógenos alimentarios.
El proyecto, financiado por fondos FEADER y liderado por Itacyl, se desarrolla en colaboración con varias industrias cárnicas de Castilla y León, una región que destaca por su relevancia en el sector. Con más de 800 industrias cárnicas, Castilla y León representa algo más del 26 % del total de empresas agroalimentarias de la comunidad, y produce aproximadamente el 12,5 % del volumen total de carne en España. Esta producción se refleja en la alta calidad de los productos de la región, respaldada por 23 figuras de reconocimiento que certifican su excelencia.
Dentro del marco de Iberic-Sensotracing, se están implementando avanzados sistemas para el control de ambientes en las zonas de producción, con especial atención a la Listeria monocytogenes, un patógeno conocido por su capacidad de proliferar en superficies y equipos dentro de los entornos alimentarios. Este control se lleva a cabo mediante innovadores sensores de control de higiene que simulan con eficacia las condiciones del entorno de procesado de alimentos, ofreciendo una alternativa eficiente a los métodos convencionales de muestreo de superficies.

Además, el proyecto ha desarrollado un sistema de identificación genética que discrimina entre diferentes cepas de Listeria a lo largo de la cadena de producción. Esto permite identificar las cepas más resistentes a desinfectantes y condiciones ambientales, un factor clave para garantizar la seguridad alimentaria en la industria cárnica.
La industria cárnica de Castilla y León es el principal sector dentro de la industria de alimentación y bebidas en España, y la implementación de estas tecnologías no solo mejora la seguridad de los productos, sino que también refuerza la posición de la región como líder en innovación tecnológica. Este avance es crucial para consolidar el crecimiento del sector, favoreciendo un aumento en el desarrollo comercial y en las exportaciones de productos cárnicos de alta calidad.

Deja un comentario